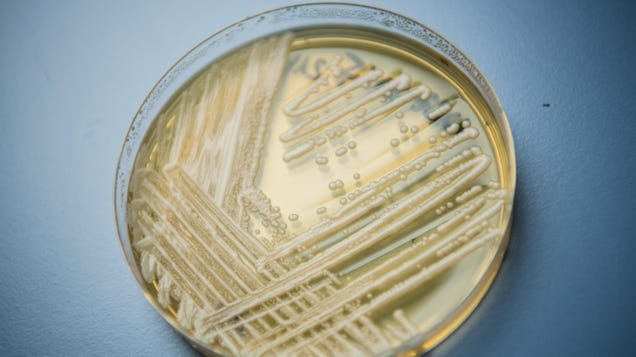

A worrying superbug fungus has been spotted in Louisiana for the first time. On Tuesday, hospital officials reported that at least two patients at the University Medical Center in New Orleans had contracted Candida auris, a deadly yeast often resistant to antifungals that can spread quickly in hospitals. The cases…
Source: Gizmodo – Deadly Superbug Fungus Spotted in Louisiana for the First Time